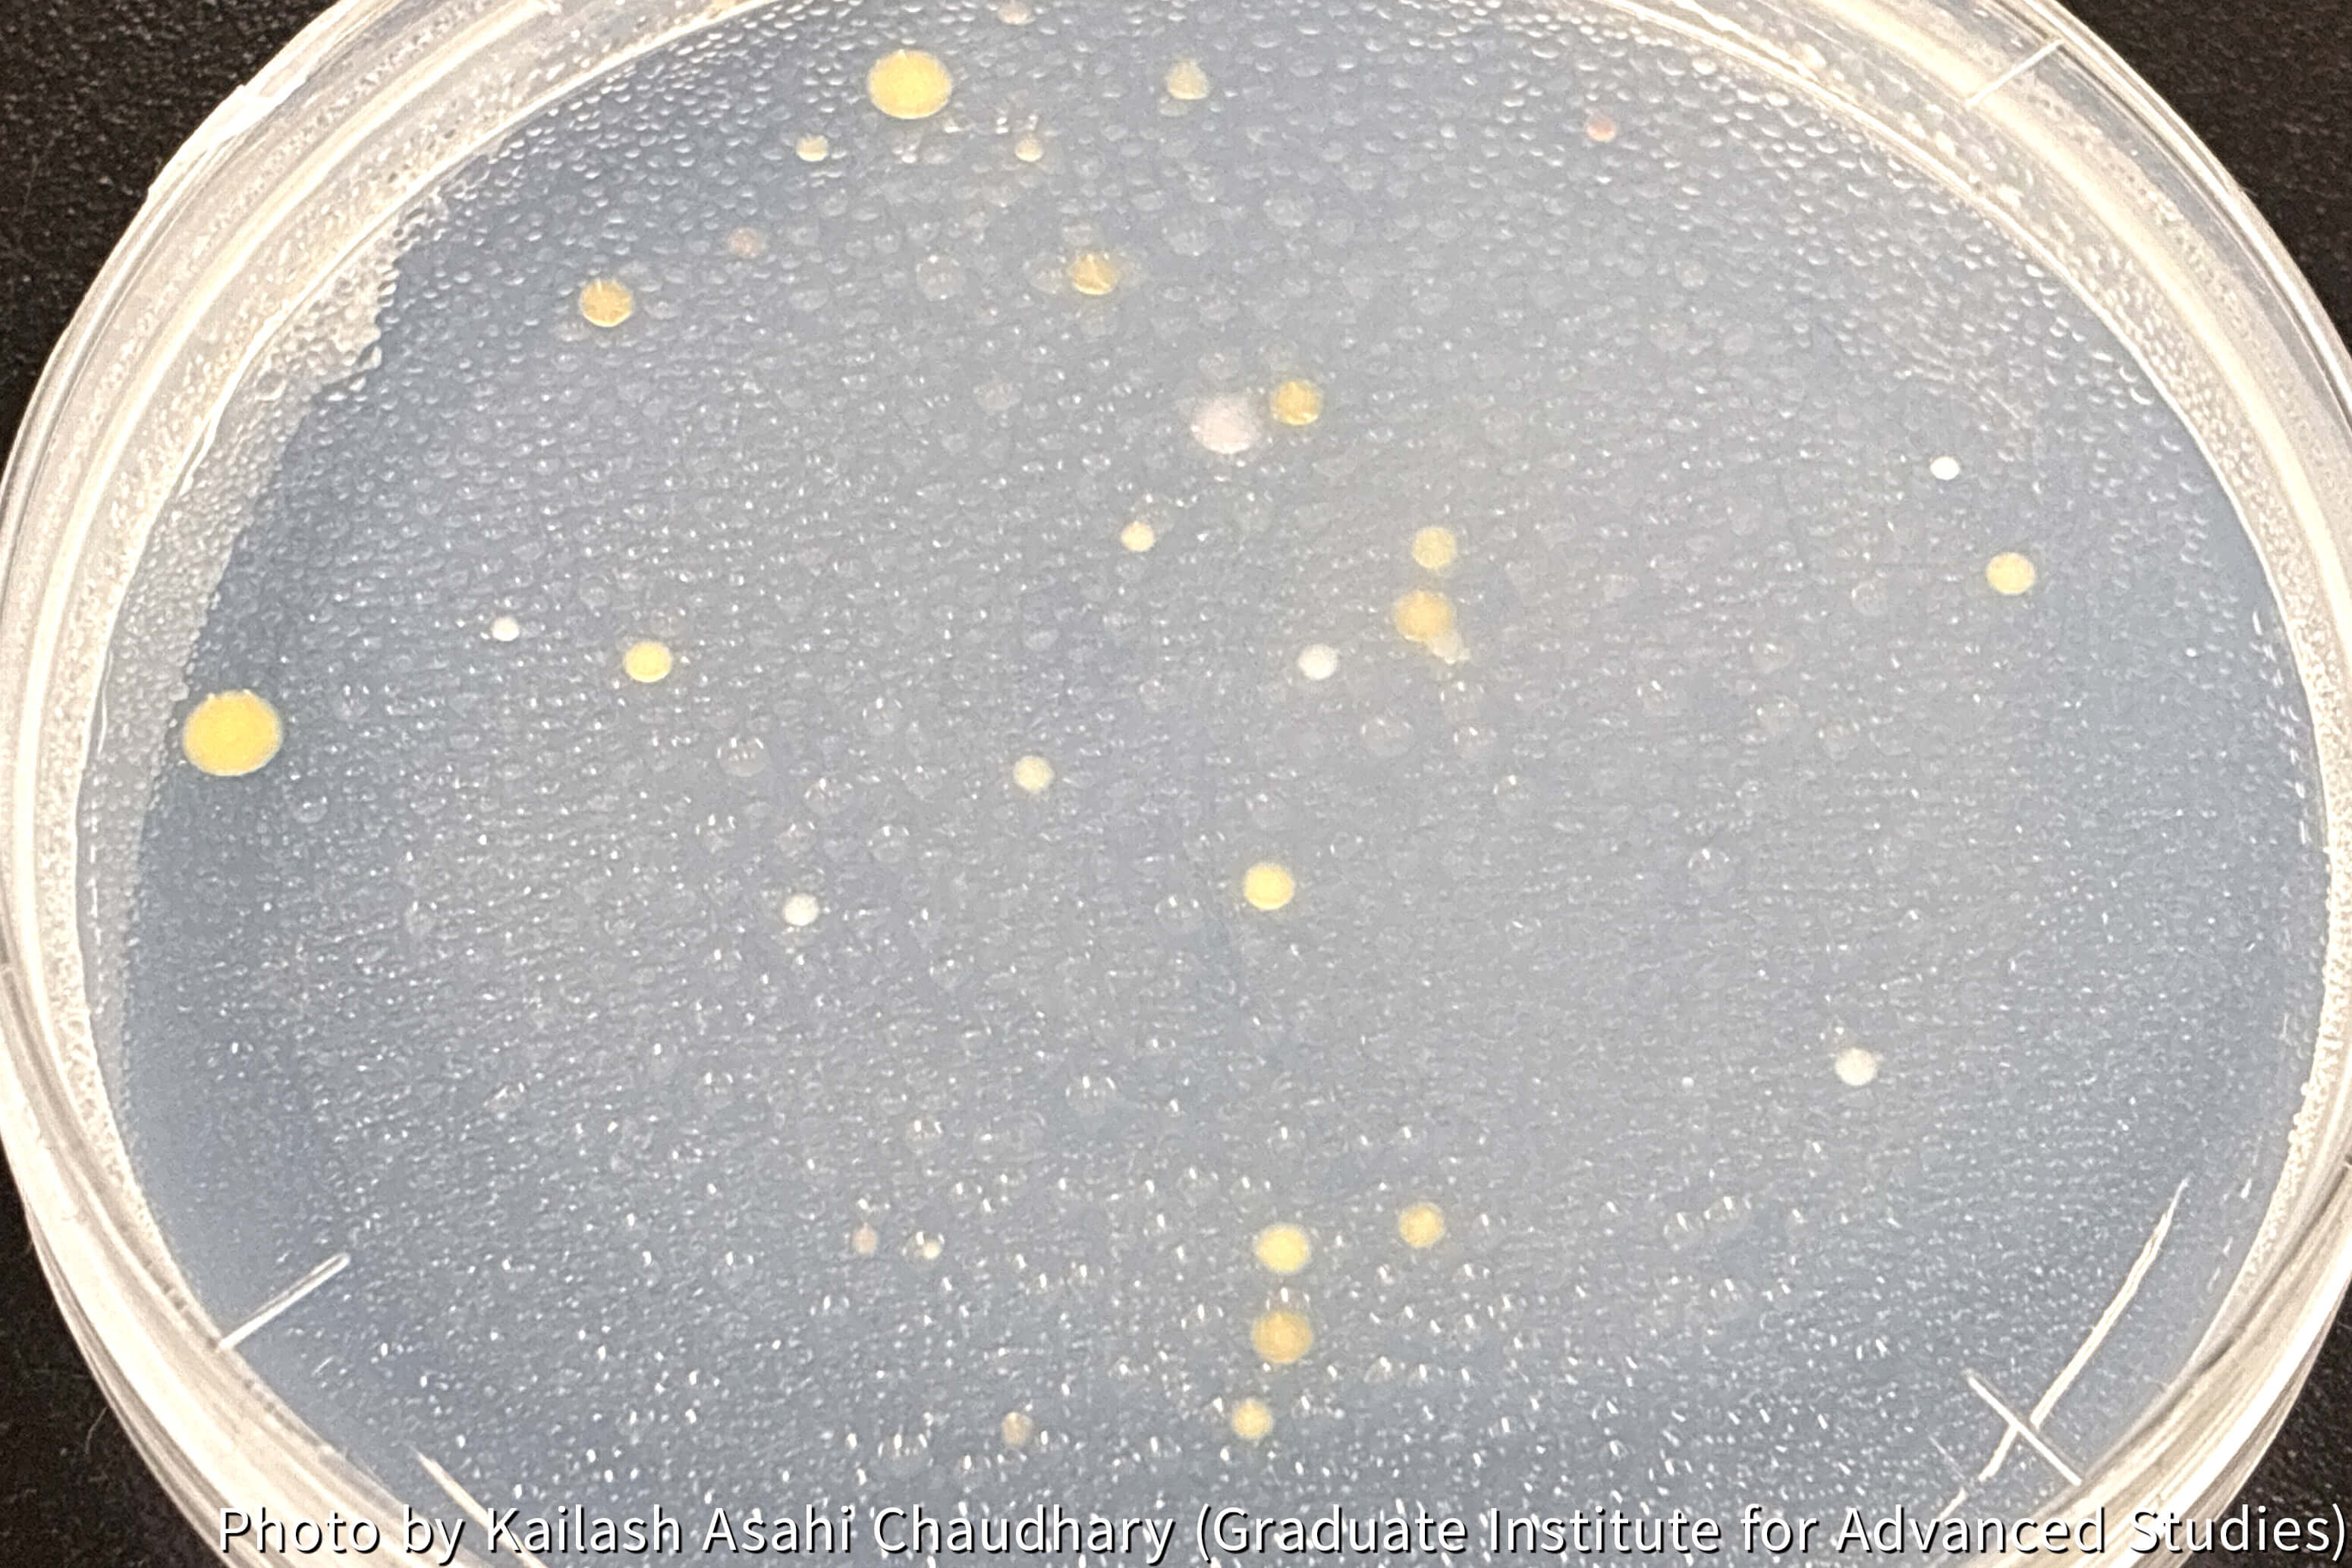

Release date
Microbiological Survey in the Brøgger Glacier Region, Norwegian Arctic ~My First Field Research in Svalbard~
Post Date:
Author: Kailash Asahi Chaudhary (Graduate Institute for Advanced Studies)
In July 2025, I visited Ny-Ålesund, Svalbard, Norway. It was my first time in the Arctic! The buildings in Ny-Ålesund feature a Nordic architectural style, and their contrast with the distant mountains, snow, and glaciers creates a beautiful scene (Photo 1). For fieldwork, I headed to an outwash plain at the foot of a glacier (Photo 2).
Outwash plains are landforms shaped by meltwater flowing from glaciers. They are known as one of the main sources of dust in the atmosphere. My study focuses on microorganisms within them. Some airborne microbes can act as ice nuclei, playing a role in cloud formation and precipitation. By investigating these microbial sources and ice nuclei characteristics, I aim to clarify how local microorganisms influence weather and future climate change.
I collected sediment samples from both the East and West Brøgger Glaciers, extending downstream into their outwash plains (Photos 3 and 4). The rocky terrain and strong meltwater streams leading toward the glaciers were striking (Photos 5 and 6). Working in the cold wind and light rain while wearing thin rubber gloves gave me a real sense of conducting research in a polar region.
Back at the NIPR station in Ny-Ålesund, I conducted cultivation experiments on the collected sediments (Photo 7). As microbes grew, various types of colonies began to appear on the culture media (Photo 8). Could some of these microorganisms have the ability to act as ice nuclei? By isolating and cultivating each colony, I am exploring their potential role in ice crystal formation.
Frequent polar bear sightings necessitate constant vigilance during fieldwork. I received polar bear alerts near the glaciers, and even close to Ny-Ålesund. During one field research, we spotted a polar bear walking leisurely along a cliff in the direction of our field site (Photo 9). For safety reason, we quickly returned to our station. It was a rare and unforgettable experience, feeling both the danger and the awe of seeing such a magnificent animal in the wild.